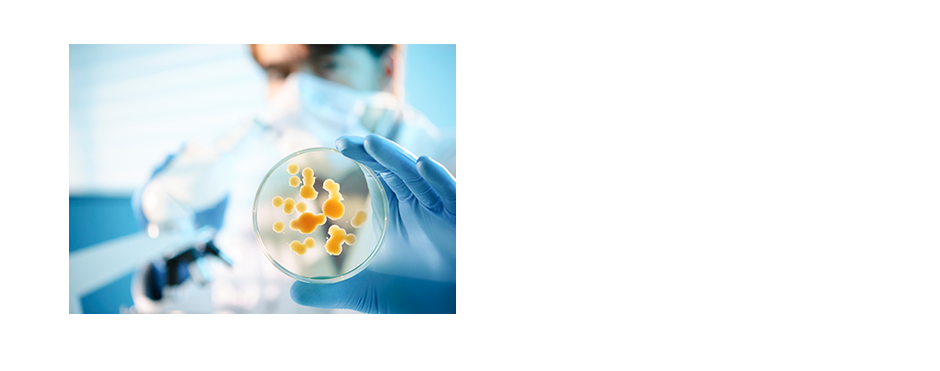

-

Highly Experienced Technicians
With more than two decades’ experience, a staff of highly experienced technicians, managers and administrative staff, and some of the latest technology in the industry, I.G. MicroMed can test for an extensive range of bacteria, mold, yeast, fungi, algae, allergens and toxins. We can help you identify the most appropriate test for your product. -

Accredited
The I.G. MicroMed laboratory is accredited by the Standards Council of Canada under ISO 17025, designated by the Province of BC as a certified laboratory for drinking water testing.
For more information, click to download either our IG MicroMed SCC Scope of Accreditation under ISO/IEC 17025 for testing on Foods and Edible Products (Human and Animal Consumption) or our IG MicroMed SCC Certificate of Accreditation.To view a copy of our EWQA license, please click here.
-

Quality Control
If you process or distribute a product that people consume or use topically, you should be in need of our services for regular quality control analysis and to prove that you meet quality assurance requirements and standards.